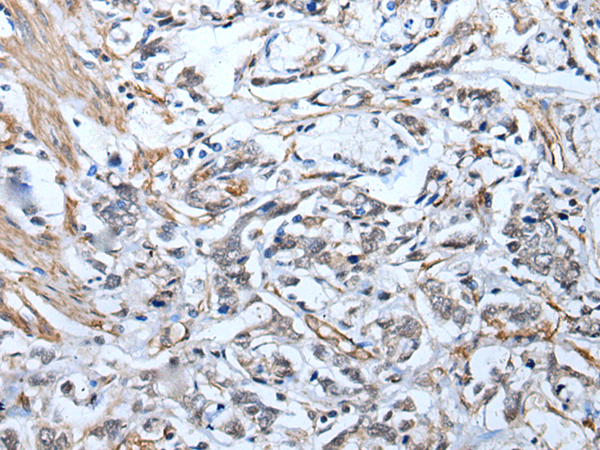

|
Background: |
The protein encoded by this gene contains a STE20-like kinase domain, but lacks several residues that are critical for catalytic activity, so it is termed a 'pseudokinase'. The protein forms a heterotrimeric complex with serine/threonine kinase 11 (STK11, also known as LKB1) and the scaffolding protein calcium binding protein 39 (CAB39, also known as MO25). The protein activates STK11 leading to the phosphorylation of both proteins and excluding STK11 from the nucleus. The protein is necessary for STK11-induced G1 cell cycle arrest. A mutation in this gene has been shown to result in polyhydramnios, megalencephaly, and symptomatic epilepsy (PMSE) syndrome. Multiple transcript variants encoding different isoforms have been found for this gene. Additional transcript variants have been described but their full-length nature is not known. |
|
Applications: |
ELISA, IHC |
|
Name of antibody: |
STRADA |
|
Immunogen: |
Full length fusion protein |
|
Full name: |
STE20-related kinase adaptor alpha |
|
Synonyms: |
LYK5; PMSE; Stlk; STRAD; NY-BR-96 |
|
SwissProt: |
Q7RTN6 |
|
ELISA Recommended dilution: |
5000-10000 |
|
IHC positive control: |
Human esophagus cancer and human gastric cancer |
|
IHC Recommend dilution: |
30-150 |
購物車
幫助
021-54845833/15800441009
